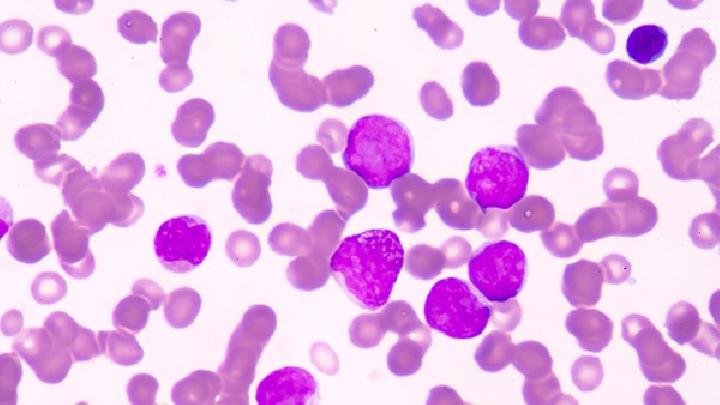
先天性梅毒的发病原因有哪些

在生活中,我们都不会对先天性梅毒感到陌生。症状出现后,要选择积极治疗的态度。只要积极配合医生检查治疗,先天性梅毒疾病就会恢复。接下来,让我们来看看先天性梅毒的原因!
【病因】
1. 感染源是梅毒患者和隐性梅毒孕妇。梅毒螺旋体可以通过完整的皮肤或粘膜进入体内。早期梅毒皮肤粘膜损伤的分泌物含有大量的病原体,具有很强的传染性。随着病程的进展,传染性越来越小,通过直接或间接接触感染较少。
梅毒螺旋体细长,5-15×0.1-0.2UM,细弹簧,螺旋弯曲规则,平均8-14一个,两端都是直的。在电镜下,梅毒螺旋体结构复杂,从外到内分为:外膜(主要由蛋白质、糖和脂肪组成)、轴线(主要由蛋白质组成)、圆柱形菌体(包括细胞壁、细胞膜和细胞浆内容物),一般染料不易着色。梅毒螺旋体有生命发育周期,分为颗粒期、球体期和螺旋体期,平均增殖约30小时,与疾病周期、隐伏发作和慢性病程有关。梅素螺旋体抗原分为三类:
1.螺旋体表面特异性抗原:刺激机体产生特异的凝固抗体和致密螺旋体制动或溶解抗体,后者可溶解螺旋体。
2.螺旋体内类属抗原:可产生补体结合抗体,与非病原螺旋体交叉反应。
3,螺旋体与宿主组织磷脂形成的复合抗原:当螺旋体侵入组织时,组织中的磷脂可以粘附在螺旋体上,形成复合抗原。这种复合抗原可以刺激身体产生自身的抗磷脂免疫抗体,称为反应素(AEGAGIN),沉淀反应(康氏试验)或补体结合反应(华氏试验)可与从牛心肌或其他正常动物心肌中提取的类脂质抗原发生。
1981年,FIELDSTEEL棉尾兔单层上皮细胞在微氧条件下成功培养,不能在人工培养基上培养。
梅素螺旋体对温度和干燥特别敏感,离体干燥1-2小时死亡,41℃一小时死亡,对化学消毒剂敏感,1-2%石炭酸在几分钟内死亡,对青霉素、四环素、砷等敏感。
2. 胎盘是先天性梅毒的主要传播途径。妊娠4个月后,由于绒毛膜细胞营养层萎缩,梅毒螺旋体可通过胎盘感染胎儿。近年来,通过电子显微镜检查发现,梅毒螺旋体可以在妊娠早期、中期和晚期通过胎盘感染胎儿。
【发病机制】
人们普遍容易感染梅毒。到目前为止,梅毒的致病机制还不是很清楚。梅毒螺旋体通过母体胎盘进入胎儿后,在肝、脾、肾上腺等内脏组织中大量繁殖,释放血液,可引起皮肤、粘膜、骨骼、血液、内脏病变,严重者可引起流产、早产、死产。主要病理变化包括血管内皮细胞肿胀、增生、管腔闭塞、远端局部坏死或奶酪变化,或纤维组织增生形成疤痕,损害器官结构和功能。

我们都知道先天性梅毒的很清楚,在生活中我们应该采取相应的治疗,我们不让先天性梅毒疾病发生在我们身上,及时发现疾病及时治疗,在生活中预防,避免类似的疾病。
亲身体验祛疤 两次 祛疤、祛疤~~~ 冷冻祛疤后,疤痕消失了,但疤痕还在~
